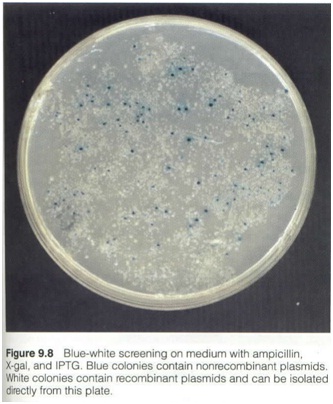
Recombinant DNA

Published on Feb 13, 2025
The goal of this experiment is to study about-Recombinant DNA Technology In Today’s Medicine.
Genetic Engineering plays a very important role, not only in scientific research, but also in the diagnosis and treatment of disease. Recombinant DNA is a tool in understanding the structure, function, and regulation of genes and their products.
The objectives of Recombinant DNA technology include:
– Identifying genes
– Isolating genes
– Modifying genes
– Re-expressing genes in other hosts or organisms
These steps permit scientists and clinicians to:
– Identify new genes and the proteins they encode
– To correct endogenous genetic defects
– To manufacture large quantities of specific gene products such as hormones, vaccines, and other biological agents of medical interest
Genetic engineering produces proteins that offer advantages over proteins isolated from other biological sources. These advantages include:
– High purity
– High specific activity
– Steady supply
– Batch-to-batch consistency
Recombinant technology begins with the isolation of a gene of interest. The gene is then inserted into a vector and cloned. A vector is a piece of DNA that is capable of independent growth; commonly used vectors are bacterial plasmids and viral phages. The gene of interest (foreign DNA) is integrated into the plasmid or phage, and this is referred to as recombinant DNA.
Before introducing the vector containing the foreign DNA into host cells to express the protein, it must be cloned. Cloning is necessary to produce numerous copies of the DNA since the initial supply is inadequate to insert into host cells.
Once the vector is isolated in large quantities, it can be introduced into the desired host cells such as mammalian, yeast, or special bacterial cells. The host cells will then synthesize the foreign protein from the recombinant DNA. When the cells are grown in vast quantities, the foreign or recombinant protein can be isolated and purified in large amounts.
Recombinant DNA technology is not only an important tool in scientific research, but has also resulted in enormous progress in the diagnosis and treatment of certain diseases and genetic disorders in many areas of medicine.
People may be tested for the presence of mutated proteins that may be involved in the progression of breast cancer, retino-blastoma, and neurofibromatosis
Tests exist to determine if people are carriers of the cystic fibrosis gene, the Huntington’s disease gene, the Tay-Sachs disease gene, or the Duchenne muscular dystrophy gene.
Scientists are able to link mutations and disease states to specific sites on chromosomes.
People suffering from cystic fibrosis, rheumatoid arthritis, vascular disease, and certain cancers may now benefit from the progress made in gene therapy.
Once gene modification becomes successful, alteration of genes to produce a more functional protein than the endogenous protein may become possible, opening up the route of gene therapy.
Researchers may now employ rational drug design to synthesize drug compounds that will be efficacious and selective in treating disease.
Insulin, growth hormone, follicle-stimulating hormone, as well as other proteins, are now available as recombinant products. Physicians will no longer have to rely on biological products of low purity and specific activity from inconsistent batch preparations to treat their patients
Restriction enzymes used to cut out insulin gene and to cut a bacterial (E. coli) plasmid at the same “sticky ends”
Mutant strains of E. coli used to avoid bacteria attacking “foreign” genes

Insert insulin gene next to E. coli
B-galactosidase gene which controls transcription
Bacterial cells replicate and make copies of insulin gene
Insulin protein is purified (B-galactosidase removed)
Chains are mixed and disulfide bridges form
Yeast cells provide a sterile growth medium
Final product is Humulin - chemically identical to human insulin
A vector usually contains a sequence (polylinker) which can recognize several restriction enzymes so that the vector can be used for cloning a variety of DNA samples.
Colonies with recombinant plasmids are white, and colonies with nonrecombinant plasmids are blue.
Example: pUC19
Resistant to ampicillin, has (amprgene)
Contains portion of the lac operon which codes for beta-galactosidase.
X-gal is a substrate of beta-galactosidase and turns blue in the presence of functional beta-galactosidase is added to the medium.
Insertion of foreign DNA into the polylinker disrupts the lac operon, beta-galactosidase becomes non-functional and the colonies fail to turn blue, but appear white.
BACs can hold up to 300 kbs.
The F factor of E.coli is capable of handling large segments of DNA.
Recombinant BACs are introduced into E.coli by electroportation( a brief high-voltage current). Once in the cell, the rBAC replicates like an F factor.
Example: pBAC108L
Has a set of regulatory genes, OriS, and repE which control F-factor replication, and parA and parB which limit the number of copies to one or two.
A chloramphenicol resistance gene, and a cloning segment.
YACs can hold up to 500 kbs.
YACs are designed to replicate as plasmids in bacteria when no foreign DNA is present. Once a fragment is inserted, YACs are transferred to cells, they then replicate as eukaryotic chromosomes.
YACs contain: a yeast centromere, two yeast telomeres, a bacterial origin of replication, and bacterial selectable markers.
YAC plasmid ----> Yeast chromosome

DNA is inserted to a unique restriction site, and cleaves the plasmid with another restriction endonuclease that removes a fragment of DNA and causes the YAC to become linear. Once in the cell, the rYAC replicates as a chromosome, also replicating the foreign DNA.
Lentiviruses can introduce a gene of interest into cells that do not divide – simple retroviruses cannot.
This ability makes them ideal for a delivery system because most of our cells, like hemopoietic stem cells, do not divide.
A genetically stripped down amalgam of HIV components can be fashioned with a molecular switch system that turns them off in response to a common antibiotic.
This type of control allows doctors to control gene expression in people who are treated with gene therapy - If something goes wrong, the expression can be turned off.
Adenoviruses are often used as a vector in gene therapy research but they do not have the capacity to integrate their genome into the hosts genome.
The advantage to using a retrovirus is that you don’t lose the genomic sequence that is incorporated into the host DNA following cell division.
http://www.rvc.ac.uk/Extranet/DNA_1/DNA_1_intro.htm
http://library.thinkquest.org/24355/data/light/details/media/recombinantanim.html
http://www.organoninc.com/products/consumer/
NCERT TEXTBOOK
PRICIPLES OF GENETICS BY SNUTSON AND BOVERY